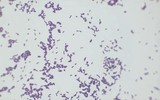

-
西海岸汉风书院“小记者站”优秀作品展示————可爱的大熊猫
大众报业·半岛网 2026-04-22 21:40 -
西海岸汉风书院“小记者站”优秀作品展示————大熊猫
大众报业·半岛网 2026-04-22 21:31 -
西海岸汉风书院“小记者站”优秀作品展示————放风筝
大众报业·半岛网 2026-04-22 21:25 -
西海岸汉风书院“小记者站”优秀作品展示————春节
大众报业·半岛网 2026-04-22 21:21 -
西海岸汉风书院“小记者站”优秀作品展示———— 我的植物朋友
大众报业·半岛网 2026-04-22 21:10 -
西海岸汉风书院“小记者站”优秀作品展示————妈妈老了,我长大了
大众报业·半岛网 2026-04-22 21:08 -
追热点丨孕妇因吃剩菜不幸去世,这个隐匿的“冰箱杀手”别忽视!
大众新闻·半岛新闻 2026-04-22 21:07 -
西海岸汉风书院“小记者站”优秀作品展示————第一次走夜路,我长大了
大众报业·半岛网 2026-04-22 21:01 -
西海岸汉风书院“小记者站”优秀作品展示————美丽的九寨沟
大众报业·半岛网 2026-04-22 20:54 -
局属公办普通高中新增学位814个,2026年普通高中综合高中招生简章发布!
大众报业·半岛网 2026-04-22 20:52 -
一枚绳结,系紧深蓝梦想
青岛理工大学 2026-04-22 20:40 -
长图站|久坐如何悄悄透支孩子的未来?警惕“安静”的陷阱!
大众新闻·半岛新闻 2026-04-22 20:13 -
世界风筝锦标赛青岛风筝协会获3金1银5铜创成绩新高,空中芭蕾舞出城市风采
大众新闻·半岛新闻 2026-04-22 20:06 -
2026年青岛市人民政府立法工作计划公布,涉及这些领域
大众新闻·半岛新闻 2026-04-22 20:06 -
日均两万人次!鲜鲅鱼上市,青岛“网红市场”再迎客流高峰
大众新闻·半岛新闻 2026-04-22 20:05 -
海报 | 英雄回家,与总书记一同致敬英雄
东北新闻网 2026-04-22 19:56 -
一见·世界地球日,看“赋能型大国”的绿色担当
人民日报客户端 2026-04-22 19:55 -
时政微观察丨在书香中赓续中华文脉
央视新闻客户端 2026-04-22 19:54 -
总书记的人民情怀 |“中国式现代化关键在科技现代化”
大众报业·半岛网 2026-04-22 19:53 -
2026年青岛普通高中综合高中招生简章发布!
大众新闻·半岛新闻 2026-04-22 19:51